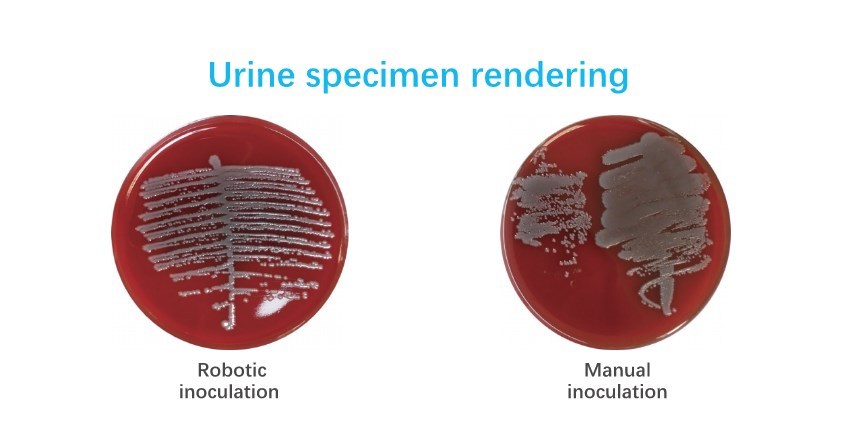
尿液标本效果图.jpg

Descripción del producto
El sistema robótico inteligente para el procesamiento de muestras microbianas adopta un brazo mecánico en lugar del procesamiento manual tradicional de muestras y la inoculación por rayado, y realiza automáticamente una serie de operaciones como enroscar la tapa, escanear el código, pegar el código, manipular, abrir la tapa, cerrar la tapa e inocular por rayado para muestras microbianas, garantizando así en gran medida la bioseguridad de los trabajadores microbianos y mejorando la eficiencia del trabajo. Estandarización del flujo de trabajo del laboratorio de microbiología.
Babio será la tecnología robótica más avanzada, tecnología de visión, tecnología de esterilización por infrarrojos, tecnología de detección de etiquetas de color, tecnología de control de movimiento, tecnología de escaneo de códigos de barras e impresión para el robot inteligente completamente automático.

Operación única con un solo clic: una vez que la muestra se coloca dentro del dispositivo, simplemente haga clic en el botón de inicio y todo el proceso comienza automáticamente, sin necesidad de configuración previa.
Una variedad de métodos de marcado flexibles: esterilización automática por infrarrojos del anillo de inoculación, marcado automático, el método de marcado es seleccionado automáticamente por el equipo de acuerdo con el tipo de muestra, o de acuerdo con los requisitos del usuario, método de marcado personalizado especial.
Cómodo procesamiento automatizado: el tubo de muestra identifica automáticamente el código de barras, se agita, abre la tapa y cierra la tapa después de sumergir la muestra; el medio de cultivo se abre y se cierra automáticamente después de la inoculación; tapa y etiqueta; las muestras se pueden colocar en cualquier lugar de la bandeja de muestras, sin tener que organizarlas según sea necesario, incluso durante el trabajo
Añade muestras en cualquier momento.
Función de monitoreo en tiempo real: Tecnología de visión única, monitoreo en tiempo real del proceso de procesamiento de la muestra y retroalimentación en tiempo real a la interfaz hombre-máquina, que incluye: tubo de prueba actual, información de la muestra, método de marcado, recuento de medio de cultivo completado, recuento de tubos de muestra completado, estado actual del equipo, etc.
Características de uso seguro: Un sofisticado sistema de filtración bacteriana en tiempo real, acoplado con lámparas ultravioleta, garantiza la esterilidad en el área de trabajo.
.
ET-2000:
.
T80

P: ¿Es usted una empresa comercial o un fabricante?
A: Somos fabricantes, centrándonos principalmente en el desarrollo y producción de medios de cultivo microbianos.
P: ¿Cuánto tiempo dura el envío?
R: Por lo general, demora alrededor de 7 días hábiles después de recibir el depósito, depende de la cantidad.
P: ¿Ofrecen muestras? ¿Son gratuitas o tienen un coste adicional?
R: Sí, podemos ofrecer muestras de la mayoría de los productos de forma gratuita, pero no pagamos el costo del flete.
P: ¿Puedes diseñar para nosotros?
R: Por supuesto, aceptamos varios pedidos OEM y ODM.
P: ¿Cómo pago?
R: Puede pagarnos mediante transferencia bancaria, transferencia bancaria, PayPal, etc.
P: ¿El precio marcado es negociable?
R: El precio es negociable en función de la cantidad del pedido.
P: ¿Cuántos tipos de productos tenéis?
R: Hay muchos tipos. Los productos más populares incluyen medios de transporte de virus, hisopos para muestreo, equipos de prueba, bolsas de recolección de sangre y equipos de transfusión, medios de polvo seco, etc. Los productos son populares en muchos países y esperamos cooperar con usted.
P: ¿Cómo podemos garantizar la calidad?
A:Siempre una muestra de preproducción antes de la producción en masa;Siempre inspección final antes del envío;
P: ¿Por qué debería comprar con nosotros y no con otros proveedores?
A: Años de experiencia en investigación y desarrollo en el campo de los consumibles médicos. Sistema de gestión de calidad en estricta conformidad con los requisitos de producción de la norma ISO13485.
Mensaje en línea
Productos recomendados
Por favor danos un mensaje